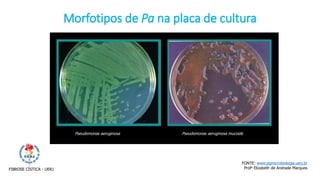
Pseudomonas aeruginosa Pseudomonas aeruginosa mucoide
Morfotipos de Pa na placa de cultura
FONTE: www.pgmicrobiologia.uerj.br
Profa Elizabeth de Andrade MarquesFIBROSE CÍSTICA - UERJ

O documento discute pneumonia, suas causas, classificações e agentes etiológicos. Aborda as principais bactérias causadoras como Streptococcus pneumoniae e Haemophilus influenzae, além de vírus, fungos e outros patógenos. Também descreve a fibrose cística e Pseudomonas aeruginosa como agente frequente nesses pacientes.